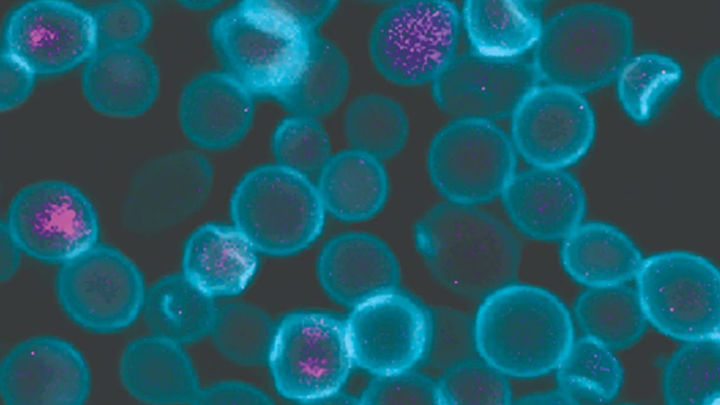

Метиленовый Синий Омикрон

🛑 👉🏻👉🏻👉🏻 ВСЯ ИНФОРМАЦИЯ ДОСТУПНА ЗДЕСЬ, ЖМИ 👈🏻👈🏻👈🏻
Метиленовый синий раствор - инструкция по применению, цена . . .
Метиленовый синий помогает бороться с ковидом? | Купрум
«Синька» против коронавируса: как появилось открытие . . .
Метиленовый синий: ноотропные свойства, инструкция по . . .
Метиленовый синий - инструкция, применение
Метиленовый синий - инструкция, применение, показания . . .
Синь метиленовая (синька): инструкция по применению от . . .
Метиленовая синька (метиленовый синий): применение . . .
Водный раствор метиленовой сини инструкция по применению
Метиленовый синий: инструкция + цена в аптеках | Tabletki .ua
Для Чего Нужен Мельдоний
Что Лечит Лориста Таблетки
Лоратадин Показания
Метиленовый синий - описание и инструкция предоставлены справочником лекарственных средств «Видаль» Предоставленная информация о ценах на препараты не является предложением о продаже или покупке товара .
Метиленовый синий, или метилтиониния хлорид, — это соль, которую в растворенном виде используют в качестве антисептика либо раствора для инъекций . С помощью метиленового синего лечат метгемоглобинемию: препарат превращает метгемоглобин в более эффективный тип гемоглобина, который лучше переносит кислород .
МС обладает и ярким противовирусным эффектом . В 2018 году было доказано, что метиленовый синий инактивирует в плазме крови вирус Эбола и коронавирус MERS-CoV, вызывающий острый ближневосточный респираторный синдром . Помимо этого, раствор метиленового синего известен как фотосенсибилизатор .
Метиленовый Синий (МС, Methylene blue) - это синтетический ноотропный препарат, который стал популярен благодаря своим свойствам улучшать настроение,
Метиленовый синий - антисептическое средство для наружного и внутривенного применения, оказывающее ранозаживляющее действие .
Метиленовый синий — инструкция, применение, показания Любые заболевания полости рта переносятся вдвойне тяжелее, поскольку не только привносят дискомфорт в существование, но и значительно снижают качество жизни .
«Синий препарат», инструкция по применению которого указана ниже, представляет собой жидкость синего цвета . Имеет в своем составе основное вещество — метилтиониния хлорид и этанол .
Метиленовый синий Препарат относится к группе анилиновых красителей . Раньше Метиленовый синий применялся очень широко в хирургии, дерматологии как антисептическое средство для обработки кожи и слизистых оболочек .
Водный раствор метиленовой сини инструкция по применению - Узнайте, раствор Метиленовый синий - кому нужно принимать, методы приема, дозировка во всех случаях, когда запрещено принимать, упаковка .
Полная информация по Метиленовый синий: инструкция, цени в аптеках, похожие товары, способ применения . Средняя цена 14 .40 - 96 .16 грн .
Мелоксикам Вертекс 15 Мг Цена
Саксенда Гормон
Аналоги Эутирокса И Л Тироксина
Нимесулид Таблетки Цена В Рязани
Кардиомагнил Фото Таблеток 75 Мг
Протаргол При Грудном Вскармливании
Мотилиум Для Детей 4 Лет
Кетопрофен Акос Гель 5 100г
Уколы Кетонал Болючие
Экофомурал При Беременности
Индометацин Таблетки При Месячных Отзывы
Фталазол Латынь
Разложение Гидроксида Железа Три
Бруснивер Цена В СПб
Таблетки Для Спортсменов Милдронат
Пивные Дрожжи Иммуномодулятор
Эскапел Через Неделю Пошла Кровь
Дала Крысе Валосердин Она Умерла
Дексалгин Мазь Цена Отзывы
Пикамилон И Церетон Одновременно Можно Принимать
Аналоги Кардиомагнила Без Ацетилсалициловой Кислоты
Раствор Лидокаина 2 Процентный
Глюкозамин Хондроитин Animal Flex
Превенар 13 Взрослым На Сколько Лет
Остеостатикс Инструкция По Применению
Селенцин Таблетки Для Волос Цена И Отзывы
Гексикон Болит Низ Живота
Тилорон Инструкция Цена Отзывы
Аптека Апрель Солпадеин
Doppelherz Aktiv Коэнзим Q10
Магнелис В6 Цена В Тольятти
Лечение Изосорбидом
Свечи Релиф Цена В Спб Аптека
Фуросемид И Верошпирон Сравнить
Анастрозол И Тамоксифен Отличия
Карведилол От Чего Помогает
Энтеросгель Омепразол Совместимость
Интервал Между Приемом Парацетамола И Ибупрофена
Ретч Таблетки Инструкция По Применению Отзывы
Магнерот Цена В Воронеже
Крем Фуцикорт Цена Омск
Бускопан Цена
Клиндацин Свечи Цена Аналог Российский
Элицея Набор Веса Отзывы
Насобек Аналог Назонекса
Найз Сайт
Снуп Или Називин
Дексаметазон Сколько Таблеток В Упаковке
Пенталгин 5 Процентов
Перманганат Калия Хлорид Аммония
Миропристон Цена В Аптеке Курск
Адиарин Регидрокомплекс И Регидрон Отличия
Хилак Форте При Гв Форум
Софрадекс При Аденоидах
Пироксикам Для Суставов
Визин Темптейшн Альбомы
Вторая Прививка Пентаксим Как Переносится
Милдронат 500 Мг Цена В Москве
Транексам И Утрожестан Одновременно
Фуросемид При Беременности На Ранних Сроках
Паксил Отзывы Врачей Психотерапевтов
Феварин 150
Прегнотон Производитель
Цистон Стоимость
Мирамистин В Тайланде Отзывы
Лейкостим Режим Дозирования
Этилметилгидроксипиридина Сукцинат Ethylmethylhydroxypyridine Succinate
Возьми Димедрола
Магний В 6 Миофарм
Донормил Курс
Иммуноглобулин G Кп
Поправляешься Ли От Фемостона Конти
Результат Иммуноглобулин Е В Сыворотке Ige
Целлекс Отзывы Форум
Цитофлавин Инструкция По Применению Уколы Внутримышечно
Крем Apieu С Кальцием Отзывы
Галавит Цена Волгоград
Консилар Д24
Кветиапин Смертельная Доза Для Человека
Ингавирин Дешевый
Лидаза В Неврологии
Слабилен Время Действия
Зоэли Цена
Веледа Детский Крем С Календулой Отзывы
Свечи Гексикон Кровь
Ацеклофенак И Диклофенак В Чем Разница Мазь
Почему Нитроглицерин Взрывается
Противорвотные Препараты Латран
Кальций Отвечает За Процессы Свертывания Крови
Таблетки Сирдалуд Инструкция
Структум Капс 500мг No 60
Расторопша В Домашних Условиях
Гинкго Двулопастный Препараты
Таблетки Ципролет Это Антибиотик Или Нет 500
Мужчинам При Планировании Сколько Фолиевой Кислоты
Контролок Отзывы Врачей
Как Понять Антагонисты Кальция
Метронидазол Свечи Цена Уфа
Нимесил Порошок Цена В Екатеринбурге Живика
Грипмакс Нос Детский Отзывы Врачей
Метиленовый Синий Омикрон

-monastyrische)-metilenovyj-sinij-1-vodno-spirtovyj-rastvor-20-ml-20.jpg">
-monastyrische)-metilenovyj-sinij-1-vodno-spirtovyj-rastvor-10-ml-20.jpg">



imgsize-517082">resizemode-4">msid-84496063/vaccine-offers-99-protection-against-death-in-delta-strain-finds-niv-study.jpg">


















imgsize-229943">resizemode-4">msid-83462524/southern-railway-delivers-over-4000-mt-medical-oxygen-to-tamil-nadu.jpg">












-ternopol-)-zubnye-kapli-rastvor-zubnoj-flakon-10-ml-20.png">
















